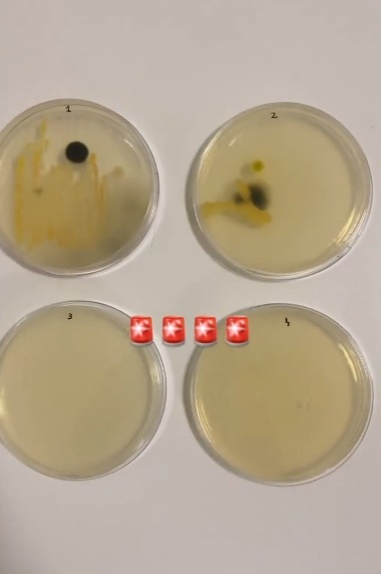

캔 콜라 입대고 마신 면 큰일난데요!!


















(움직이는 짤 나옴)































(움직이는 짤 나옴)